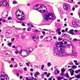
Cancer

-
The oldest available specimen of a human cancer is found in the remains of skull of a female who lived during the Bronze Age (1900-1600 BC) The tumor in the womens skull was suggestive of head and neck cancer. The mummified skeletal remains of Peruvian Incas, dating back 2400 years ago, contained abnormalities suggestive of involvement with malignant melanoma. Cancer was also found in fossilized bones recovered from ancient Egypt. Louis Leakey found the oldest possible hominid malignant tumor in
-
Human cancer is probably as old as the human race. It is obvious that cancer did not suddenly start appearing after modernization or industrial revolution. The oldest known description of human cancer is found in an Egyptian seven papyri or writing written between 3000-1500 BC. Two of them, known as the "Edwin Smith" and "George Ebers" papyri, contain details of conditions that are consistent with modern descriptions of cancer. The Edwin Smith Papyrus, describes 8 cases of tumors or ulcers of th
-
During the beginning of the 15th Century scientists developed greater understanding of the workings of human body and its disease processes. Autopsies, done by Harvey (1628), led to an understanding of the circulation of blood through the heart and body.
-
Giovanni Morgagni of Padua in 1761 regularized autopsies to find the cause of diseases. This laid the foundation for the study of cancer as well. It was Scottish surgeon John Hunter (1728−1793) who suggested that some cancers might be cured by surgery. It was nearly a century later that development of anesthesia prompted regular surgery for “movable” cancers that had not spread to other organs.
-
Immunotherapy is also sometimes called biologic therapy or biotherapy. It is treatment that uses certain parts of the immune system to fight diseases such as cancer. This can be done in a couple of ways:1.Stimulating your own immune system to work harder or smarter to attack cancer cells2.Giving you immune system components, such as man-made immune system proteins
-
Radiation therapy uses high-energy radiation to shrink tumors and kill cancer cells (1). X-rays, gamma rays, and charged particles are types of radiation used for cancer treatment.
The radiation may be delivered by a machine outside the body (external-beam radiation therapy), or it may come from radioactive material placed in the body near cancer cells (internal radiation therapy, also called brachytherapy).
Systemic radiation therapy uses radioactive substances, such as radioactive iodine -
chemotherapy means the use of any drug (such as aspirin or penicillin) to treat any disease, but to most people chemotherapy refers to drugs used for cancer treatment.
-
Cancer surgery — an operation to repair or remove part of your body to diagnose or treat cancer — remains the foundation of cancer treatment. Your doctor may use cancer surgery to achieve any number of goals, from diagnosing and treating your cancer to relieving the symptoms it causes. Cancer surgery may be your only treatment, or it may be supplemented with other treatments.
-
One in three people will contract cancer, and one in four will die from the disease. Within five years, cancer will surpass heart disease as the leading cause of death, according to the American Hospital Association. In 1994, 1.2 million new cancer cases were added to the more than eight million people in the U.S. who have already been diagnosed with cancer.
-
Recent research on a new carotinoid, DHIR, suggests it combines both antioxidant and UV-shielding properties in one molecule with potentially fewer side effects than other carotinoids.
-
Rudolf Virchow, often called the founder of cellular pathology, founded the basis for pathologic study of cancers under the microscope. Virchow correlated microscopic pathology to illness. He also developed study of tissues that were taken out after surgery. The pathologist could also tell the surgeon whether the operation had completely removed the cancer.
-
Worldwide, the 5 most common types of cancer that kill men are (in order of frequency): lung, stomach, liver, colorectal and oesophagus.
-
One fifth of all cancers worldwide are caused by a chronic infection, for example human papillomavirus (HPV) causes cervical cancer and hepatitis B virus (HBV) causes liver cancer.
-
Cancer screening detects cancers when they are at an early stage, or - in the case of cervical cancer screening - before they have developed. We know that screening saves thousands of lives each year. In the UK, we have three national screening programmes - for breast, cervical and bowel cancers.
-
A newly developed technique called SQUID imaging can detect 5 differents proteins found in early ovarian cancer. With further development, this new diagnostic tool may help save many women's lives from ovarian cancer - the notoriour "silent killer" which often escapes early detection and becomes too difficult to treat when eventually diagnosed.
-
Among the 12 major types of childhood cancers, leukemias (blood cell cancers) and cancers of the brain and central nervous system account for more than half of the new cases. About one-third of childhood cancers are leukemias. The most common type of leukemia in children is acute lymphoblastic leukemia. The most common solid tumors are brain tumors (e.g., gliomas and medulloblastomas), with other solid tumors (e.g., neuroblastomas, Wilms tumors, and sarcomas such as rhabdomyosarcoma and osteosar